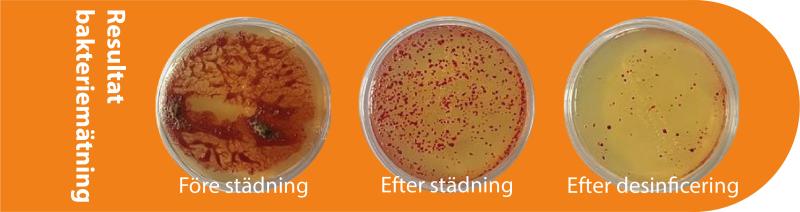

- Totalt 0 :-
Elektrostatisk fogger
För ytdesinficering, lukt- och mögelsanering
Teknologi är avgörande
Det är viktigt att komma ihåg att alla ytor omkring oss har en antingen positiv eller negativ laddning (själva jorden är negativt laddad).
För att elektrostatisk effekt skall uppnås med bäst resultat så skall applicering ske med en positiv laddning, så att de positivt laddade dropparna dras till alla negativa eller neutrala ytor.
Våra foggers tillför en positiv laddning till dropparna. När dropparna lämnar det elektrostatiska munstycket fokuserar de på att hitta alla ytor med motsatt laddning, vilket får de att sprida ut sig och omkringsluta alla ytor i 360 grader (bakom, under mm).
Precis som billackeringsindustrin upptäckte för årtionden sedan, att elektrostatisk applicering gav en jämnare täckning. Så väl under som bakom och på ytor man annars aldrig kommit åt.
Ladda ner PDF för att läsa mer:

Minion
Handhållen elektrostatisk påläggare med en räckvidd på ca 5 meter och täcker 1200 kvadratmeter per tank.

Terminator
En elektrostatisk ULV fogger med en räckvidd på hela 20 meter och täcker 8000 kvadratmeter på en tank.

EX7000 Backpack
En elektrostatisk påläggare som har en räckvidd på drygt 5 meter och täcker 4500 kvadratmeter på en tank.






